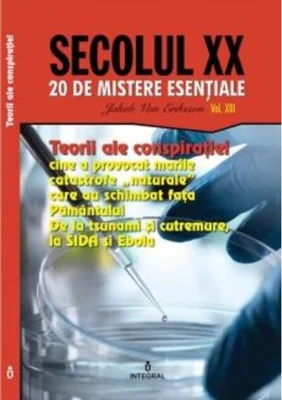
Teorii ale conspirației. Cine a provocat marile catastrofe „naturale” care au schimbat fața Pământului (Vol. 13)

Search results for "Povești"
Se afișează 4801-4825 din 6783 produse

Planeta noastră
71.99 RON

Cetatea
23.71 RON31.61 RON

Ferma distractivă. Carte de colorat. Ediție bilingvă (Română - Engleză)
16.65 RON18.5 RON

Plictisitoarea vacanţă de vară a fraţilor Răţoi
34.34 RON
Teorii ale conspirației. Cine a provocat marile catastrofe „naturale” care au schimbat fața Pământului (Vol. 13)
15.06 RON15.85 RON

A fost odată în Țara Viselor
30.4 RON32 RON

Alte povești cu tâlc
8.99 RON

Montessori de la 6 la 12 ani
41.44 RON51.8 RON

Peter Pan
20 RON

Banii
59 RON

Intervenții neobișnuite. Modificări ale cadrului, metodei și relației în psihoterapie și psihanaliză
43.65 RON

Femei și poveștile lor
24.3 RON27 RON

Dă culoare clasicilor - Aventurile lui Alice în Țara Minunilor
33.3 RON37 RON

De ce este eficientă psihoterapia
59.25 RON62.37 RON

Un musafir surpriză. Jup, un pisoi de soi (Vol.4)
44.65 RON47 RON

Fii şi îndrăgostiţi
33.2 RON36.89 RON

The Picture of Dorian Gray + Online Audio + App (Step Three B1.2)
49.4 RON

Descoperă culorile! Unicorni
37.11 RON41.23 RON

Durerea
25.11 RON26.43 RON

Fericit până la adânci bătrâneți. Cum să evadăm din mitul vieții perfecte.
37.15 RON39.11 RON

Puzzle Arthink în Formă de Sirenă, 180 Piese
91.8 RON102 RON

Pot desena minunat zâne
25 RON

O lume fără bărbați
45.67 RON50.74 RON

Povestea frumoasei Ana și a căpcăunului Codin
49.31 RON51.9 RON

Părul contează enorm
34.95 RON